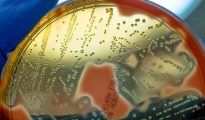

Horror warning as flesh-eating bacteria that can kill in two days spreads at record speed
In the most serious cases, the bacteria can lead to necrosis, breathing issues, organ failure and death. Daily Express :: World Feed More...

Horror warning as Putin could use nuclear weapons if he thinks he’s losing
A senior Ukrainian security official has issued a stark warning. Daily Express :: World Feed More...

Horror train crash leaves at least eight dead as rescuers scour the twisted wreckage
Doctors, disaster-response teams and ambulances were engaged in rescue work in the twisted wreckage after a cargo train slammed into a passenger carriage. Daily Express :: World Feed More...

BBC Countryfile presenter Sammi Kinghorn feared she’d die after horror accident
Countryfile presenter Sammi Kinghorn has opened up about an incident that left her paralysed from the waist down and fearing for her life. Daily Express :: Celebrity News Feed More...

Gordon Ramsay says he ‘nearly died’ in horror bike accident as he shows off injuries
Gordon Ramsay has told his fans he ‘nearly died’ after suffering a horrific road accident which left him with extensive injuries to one side of his body. Daily Express :: Celebrity News Feed More...

Horror as 28 people left trapped upside down on ‘extreme’ ride at theme park
Photos posted to social media on Friday show 28 people suspended in their seats with their feet pointed towards the sky. Daily Express :: News Feed More...

‘I thought I had heartburn but pain in the night turned into horror diagnosis’
EXCLUSIVE: Steven Haddon kept waking up at 4am with a pain in his chest and put it down to heartburn, but the truth was far more devastating. Daily Express :: Health Feed More...

Scotland crushed by Germany at Euro 2024 after horror tackle as Clarke and MacPhee clash
Scotland were thumped by Germany in the opening game of Euro 2024 on Friday evening. Daily Express :: Sport Feed More...

Birmingham Airport LIVE: Horror queues snake outside terminal after liquid rule blunder
A U-turn on hand-luggage liquid rules has caused a mass of confusion – making queues through security much worse. Daily Express :: News Feed More...

Costa Blanca horror as British tourist injured after boat burst into flames
Three people, including a British national, were rushed to hospital following an explosion in a popular holiday hotspot. Daily Express :: World Feed More...






